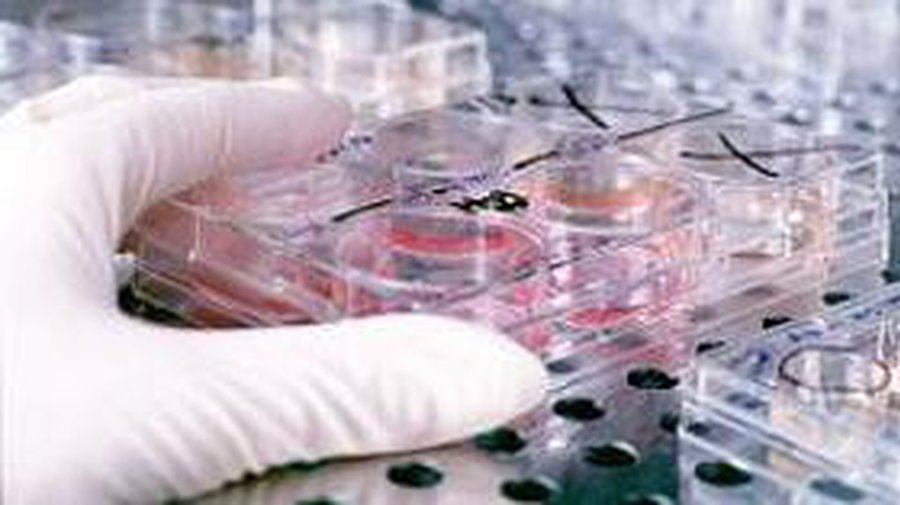
ВОЗ: Лекарства для лечения свиного гриппа уже существуют - Наука и здоровье

Лекарства для лечения свиного гриппа уже существуют :::
Представитель Всемирной организации здравоохранения (ВОЗ) Грегори Хартл на пресс- конференции в Женеве заявил, что вирус мексиканского свиного гриппа поддается лечению имеющимися лекарствами.
Лекарства, включая препарат «Тамифлю», эффективны против вируса свиного гриппа, болезнь поддается лечению, подчеркнул он.
podrobnosti.ua
ВОЗ: Лекарства для лечения свиного гриппа уже существуют
Комментарии
Для комментирования необходимо войти в аккаунт Facebook (Meta)
Наука и здоровье
другие новости раздела →
Cуд подтвердил законность применяемой в Литве Австралийской системы классификации болезней и нарушений здоровья

VMVT напоминает: с началом активного сезона клещей позаботьтесь о защите животных

Психосоциальную реабилитацию зависимым могут оказывать только лицензированные учреждения

Помело - крупный цитрус с мягким вкусом и пользой для здоровья

Мифы о здоровом питании: что подтверждено наукой, а что нет

Почему мандарины дарят ощущение новогодних праздников?

Может ли черный шоколад защищать от кариеса?
